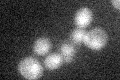
YLR376C
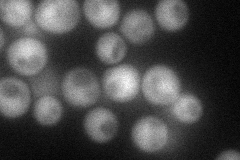
YLR376C
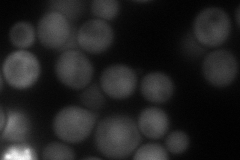
YLR376C
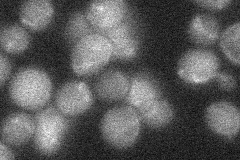
YLR376C
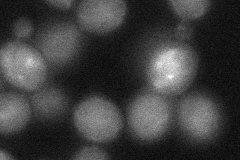
YLR376C
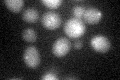
YLR376C

View description
Protein involved in a Rad51p-, Rad54p-dependent pathway for homologous recombination repair; deletion results in a mutator phenotype; deletion increases sensitivity to anticancer drugs oxaliplatin and cisplatin but not mitomycin C
Localization:
Intensity:
Fold change:
Significance:
-
C’ GFP library in SD
below threshold18.44 -
N' NOP1pr-GFP in SD
cytosol,nucleus49.5338 -
N' TEF2pr-mCherry in SD
cytosol,nucleus87.5278 -
N' NATIVEpr-GFP in SD
below threshold20.9427 -
N' TEF2pr-VC and Cyto-VN in SD
cytosol35.3108 -
C’ GFP library in SD+DTT
cytosol19.791.07No -
C’ GFP library in SD+H2O2

cytosol16.10.87No -
C’ GFP library in Starvation Media

cytosol16.470.89No -
C’ GFP library on the background of Pup2-DaMP

below threshold -
C’ GFP library on the background of CCT mutant

below threshold20.76781.126No
